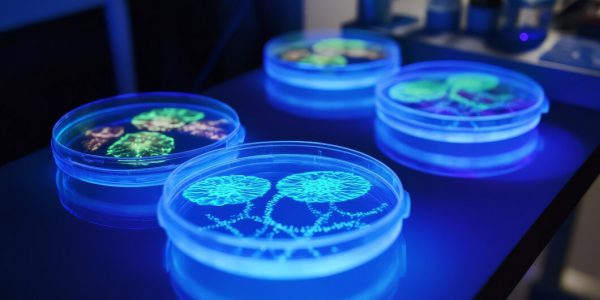

? Mitokondri Nedir? Mitokondri Görevleri ve Özellikleri Nelerdir?
Mitokondri, hücrelerin enerji santrali olarak bilinen, hücrelerin enerji üretiminde kritik bir rol oynayan organellerdir. Hem bitkilerde hem de hayvanlarda bulunan mitokondriler, hücresel solunum süreçlerinde önemli bir rol oynar ve dolayısıyla yaşamın temelini oluştururlar. Bu yazıda, mitokondrinin ne olduğu, görevleri ve…
İbni Sina’nın Sağlık Reçetelerine Kadar Uzanıyor! Osmanlı Mutfağından Günümüze Gelen Dünyaca Ünlü Lezzet Taş Değirmenlerde Öğütülüyor
Konya’nın Bozkır ilçesinde, dedesinden aldığı ustalıkla tahin üretimine devam eden 27 yaşındaki Hasan Hüseyin Turgut, kara fırında odun ateşinde 4 saat kavrulan susamdan tahin üretiyor. Bozkır tahini, ilçeye tescillendikten sonra ülke genelinin yanı sıra yurt dışı pazarına da gönderilmeye başlandı….
Araştırma Dans Etmek Beyne İyi Geliyor
Dans etmenin beyne olan olumlu etkileri, özellikle Parkinson gibi nörolojik hastalıklarla mücadelede önemli bir rol oynadığı bilimsel çalışmalarla destekleniyor. İşte detaylar: Beyin İçi Senkronizasyon: Dans etmek, beyinde yeni sinir bağlantıları oluşturarak beyin içi senkronizasyonu yeniden sağlıyor. Özellikle Parkinson hastalarında etkilenen…
Halk Arasında “Sütlü İlaç” Olarak da Biliniyor Şifa Niyetine Kaynatılıyor, Turistlerin Gözdesi Haline Geldi
Trabzon’un Maçka ilçesinde, tarihi İpek Yolu güzergahında bulunan yaklaşık 1300 rakımlı Hamsiköy, kendine has coğrafi işaretli Hamsiköy sütlacı ile yerli ve yabancı turistlerin gözdesi haline geldi. Tarihi yaklaşık bir asır öncesine dayanan ve “sütlü ilaç” olarak bilinen bu sütlaç, yörenin…
Uzmanlar Uyardı Sağlığı Mahveden 10 Alışkanlık
Bilim insanları, bazı yaygın alışkanlıkların sağlığı olumsuz etkileyebileceği konusunda uyarılarda bulundu. İşte kilo aldıran, uyku düzenini bozan ve enerjiyi düşüren 10 şaşırtıcı alışkanlık: Sabahın İlk Saatlerinde Kahve İçmek: Sabahları erken saatlerde kahve içmek susuzluğa neden olabilir. Uykudan uyandığınızda vücut zaten…
Pankreas Kanseri Neden Ölümcül? Gizem Çözüldü
Pankreas kanserinin ölümcüllüğünün nedenleri üzerine yapılan araştırmalar sonucunda önemli bir keşif yapıldı. İngiliz ve Amerikalı bilim insanları, pankreas kanserinin pankreasın DNA yapısındaki belirli bir geni etkisiz hale getirdiğini tespit ettiler. Bu keşif, hastalığın neden bu kadar agresif ve ölümcül olduğunu…
ABD’li Doktorlar Açıkladı! Böyle Beslenen Uzun Yaşıyor, Kadınlarda Ömrü 10, Erkeklerde 13 Yıl Uzatıyor
ABD’li doktorlar tarafından yapılan araştırmalar, sağlıklı ve uzun bir ömür için beslenme alışkanlıklarının önemini vurguluyor. İşte bu konuda ortaya konan bilgiler ve öneriler: Sağlıklı Beslenmenin Önemi Sağlıklı bir yaşam için beslenme düzeninizin önemi büyük. Besinler doğrudan vücudunuzun sağlığına etki eder…
Spina Bifida Nedir? Belirtileri ve Tedavi Yöntemleri Nelerdir?
Spina bifida, doğumdan itibaren var olan ve omuriliğin düzgün kapanmaması sonucu oluşan bir nöral tüp defekti olarak tanımlanır. Bu durum, omurga ve omuriliğin bazı bölgelerinde açıklıklar ve anormallikler oluşmasına yol açar. Spina bifida, çeşitli şekillerde ortaya çıkabilir ve belirtileri ile…
Astigmat Nedir, Dereceleri Nelerdir?
Astigmat, gözün korneasının veya lensinin düzensiz bir şekilde kavislenmesi sonucu oluşan ve bulanık görüntüye neden olan yaygın bir göz kusurudur. Gözün net görebilmesi için gelen ışınların kornea veya lens tarafından düzgün bir şekilde kırılması gerekmektedir. Astigmat durumunda ise bu kırılma…
Dünyanın En Ölümcül Patojeni: “Yılda Yarım Milyon İnsan Öldürüyor”
Pseudomonas aeruginosa, Dünya Sağlık Örgütü tarafından en tehlikeli patojenler listesinin başında yer alan ve yılda yaklaşık yarım milyon insanın hayatına mal olan bir bakteridir. Bu bakteri, jet yakıtlarından saf suya kadar geniş bir ortamda hayatta kalabilme özelliğine sahiptir ve hastane…